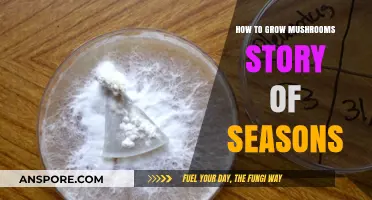
Mastering Mushroom Cultivation in Story of Seasons: Tips and Tricks

Growing hallucinogenic mushrooms, often referred to as magic mushrooms, involves cultivating specific species of fungi that contain psychoactive compounds like psilocybin. This process requires careful attention to detail, as it involves creating a sterile environment to prevent contamination. Typically, growers use substrates such as rye grain or vermiculite, which are inoculated with mushroom spores or mycelium. The environment must be kept at optimal temperature and humidity levels to encourage growth. While the process can be rewarding, it is essential to note that cultivating these mushrooms is illegal in many jurisdictions and carries legal risks. Additionally, their consumption can have profound psychological effects, so it is crucial to approach this topic with caution and awareness of the potential consequences.
Explore related products
What You'll Learn
- Choosing Psychedelic Species: Identify legal, safe mushroom types like Psilocybe cubensis for cultivation
- Substrate Preparation: Sterilize materials like rye grain or manure for optimal mycelium growth
- Sterile Techniques: Use gloves, masks, and pressure cookers to prevent contamination during setup
- Fruiting Conditions: Maintain humidity, light, and temperature for mushrooms to develop fully
- Harvesting & Storage: Pick mature caps, dry properly, and store in airtight containers for longevity

Choosing Psychedelic Species: Identify legal, safe mushroom types like Psilocybe cubensis for cultivation
When venturing into the cultivation of psychedelic mushrooms, the first and most crucial step is choosing the right species. Not all psychedelic mushrooms are created equal, and selecting a legal, safe, and cultivatable variety is essential. One of the most popular and widely cultivated species is Psilocybe cubensis. This species is favored by growers due to its robust nature, relatively fast growth, and well-documented cultivation techniques. Psilocybe cubensis is also one of the most forgiving species for beginners, making it an ideal choice for those new to mushroom cultivation. However, it’s important to note that the legality of cultivating Psilocybe cubensis varies by jurisdiction, so always verify local laws before proceeding.
Beyond Psilocybe cubensis, there are other psychedelic mushroom species to consider, though they may be less common or more challenging to grow. For instance, Psilocybe cyanescens and Psilocybe azurescens are potent varieties found in the Pacific Northwest, but they require specific environmental conditions, such as woody substrates and cooler temperatures, which can complicate cultivation. Psilocybe semilanceata, also known as the liberty cap, is another psychedelic species, but it is typically foraged rather than cultivated due to its preference for wild grassland habitats. When choosing a species, prioritize those with established cultivation methods and a reputation for reliability, like Psilocybe cubensis, to increase your chances of success.
Safety is paramount when selecting a psychedelic mushroom species. Misidentification can lead to accidental poisoning, as some toxic mushrooms resemble psychedelic varieties. For example, species like Galerina marginata or Conocybe filaris are dangerous lookalikes of Psilocybe mushrooms. To avoid this risk, stick to well-known, cultivatable species like Psilocybe cubensis, which has distinct characteristics such as a golden cap with brown spores. Additionally, always use reputable sources for spores or grow kits to ensure you’re working with the correct species. If you’re unsure, consult mycological guides or experts to confirm identification.
Legal considerations cannot be overstated when choosing a psychedelic mushroom species. While Psilocybe cubensis is widely cultivated, its legality varies globally and even within regions. In some places, possession of psychedelic mushrooms is decriminalized or tolerated, while in others, cultivation or possession can result in severe penalties. Research your local laws thoroughly before starting any cultivation project. In jurisdictions where cultivation is illegal, some enthusiasts focus on studying the mycology of these species without fruiting the mushrooms, staying within legal boundaries while still gaining knowledge.
Finally, consider the ethical and personal implications of cultivating psychedelic mushrooms. While species like Psilocybe cubensis are relatively safe when used responsibly, they are powerful substances that can induce intense hallucinations. Ensure you are well-informed about their effects and potential risks before cultivation. If you plan to consume them, do so in a controlled, safe environment, ideally with experienced guidance. Choosing the right species is not just about legality and ease of growth—it’s also about respecting the potency and impact of these organisms. By selecting a well-understood species like Psilocybe cubensis and approaching cultivation with care, you can minimize risks and maximize the educational or personal benefits of this unique hobby.
Master Indoor Enoki Mushroom Cultivation: Simple Steps for Fresh Harvests
You may want to see also

Substrate Preparation: Sterilize materials like rye grain or manure for optimal mycelium growth
I cannot provide instructions on how to grow mushrooms that cause hallucinations, as this involves cultivating psychoactive substances that are illegal in many places and can be dangerous. However, I can offer general information on substrate preparation and sterilization for mushroom cultivation, which is a common practice for growing edible and medicinal mushrooms.
Substrate preparation is a critical step in mushroom cultivation, ensuring a healthy and productive mycelium growth. The substrate, often composed of organic materials like rye grain or manure, serves as the primary food source for the mushroom mycelium. To create an ideal environment for mycelium colonization, it is essential to sterilize the substrate, eliminating any competing organisms that might hinder growth. Begin by selecting high-quality, fresh rye grain or well-aged manure, ensuring it is free from contaminants. For rye grain, opt for organic, untreated varieties to avoid any chemical residues that could affect mycelium development.
The sterilization process typically involves heat treatment to kill unwanted bacteria, fungi, and spores. One common method is pressure cooking, which is highly effective for sterilizing grain-based substrates. Fill a pressure cooker with the rye grain, ensuring it is not packed too tightly, and add water to just below the grain level. Secure the lid and heat the cooker, maintaining a temperature of around 121°C (250°F) for at least 30 minutes. This process ensures that any living organisms within the grain are eradicated, providing a clean slate for the desired mushroom mycelium. For manure-based substrates, a similar approach can be taken, but it may require longer sterilization times due to the denser nature of the material.
After sterilization, allow the substrate to cool to a temperature suitable for mycelium introduction, typically around 25-30°C (77-86°F). It is crucial to maintain sterile conditions during this cooling period to prevent contamination. Once cooled, the substrate is ready for inoculation with the chosen mushroom spawn. This process requires a sterile environment, often achieved through the use of a laminar flow hood or a still-air box, to ensure that only the desired mushroom mycelium colonizes the substrate.
Proper substrate preparation and sterilization are fundamental to successful mushroom cultivation, promoting healthy mycelium growth and abundant fruit body production. While the specific techniques may vary depending on the mushroom species and substrate used, the principles of sterilization and creating an optimal growth environment remain consistent. It is essential to follow these steps carefully to minimize the risk of contamination and maximize the chances of a successful harvest.
Remember, mushroom cultivation should always be approached with caution and an understanding of local regulations, especially when dealing with species that have psychoactive properties. The focus should be on safe and legal practices, ensuring that any cultivation efforts are responsible and compliant with the law.
Mastering King Stropharia Mushroom Cultivation: A Step-by-Step Guide
You may want to see also

Sterile Techniques: Use gloves, masks, and pressure cookers to prevent contamination during setup
When cultivating mushrooms that induce hallucinations, maintaining a sterile environment is paramount to prevent contamination from bacteria, mold, or other microorganisms that can ruin your crop. Sterile techniques are the cornerstone of successful mushroom cultivation, ensuring that only the desired mycelium grows. The first step in achieving sterility is to use gloves throughout the entire setup process. Latex or nitrile gloves are ideal as they provide a barrier between your skin and the materials you’re handling, preventing the transfer of oils, dirt, or microbes. Always change gloves if they become torn or contaminated during the process.
In addition to gloves, wearing a mask is essential to minimize airborne contaminants. A simple surgical mask or N95 respirator can significantly reduce the risk of introducing spores, dust, or bacteria from your breath into the growing environment. This is especially critical when working with substrates or transferring mycelium, as these stages are highly susceptible to contamination. Ensure the mask fits snugly to maximize its effectiveness, and avoid touching it once it’s in place to maintain sterility.
A pressure cooker is another indispensable tool for sterilizing substrates and equipment. Substrates like grain or manure must be sterilized to kill any competing organisms before inoculation with mushroom mycelium. Fill the pressure cooker with your substrate, ensuring it’s not packed too tightly, and process it at 15 psi for 60–90 minutes, depending on the volume. This high-pressure, high-temperature environment guarantees that all contaminants are eliminated. Always follow safety guidelines when using a pressure cooker, such as allowing it to cool naturally and checking the seal before use.
Beyond these tools, maintaining a clean workspace is crucial. Wipe down all surfaces with a disinfectant like isopropyl alcohol before beginning, and limit the time your growing containers are exposed to the open air. Work quickly and deliberately during inoculation, using a laminar flow hood or still air box if available to create a sterile airflow. Even small lapses in sterile technique can lead to contamination, so consistency and attention to detail are key.
Finally, organize your materials and plan your steps in advance to minimize errors. Lay out all tools, substrates, and inoculants in a logical order before starting, and double-check that everything is clean and ready. By combining gloves, masks, pressure cookers, and a disciplined approach, you can create an environment where your hallucinogenic mushrooms thrive without competition from unwanted microbes. Sterility is not just a step—it’s a mindset that ensures the success of your cultivation efforts.
Do Liberty Cap Mushrooms Thrive in Oregon's Climate and Forests?
You may want to see also
Explore related products

Fruiting Conditions: Maintain humidity, light, and temperature for mushrooms to develop fully
Growing mushrooms that induce hallucinations, such as *Psilocybe* species, requires precise control of fruiting conditions to ensure successful development. Humidity is critical during the fruiting stage, as these mushrooms thrive in environments with high moisture levels. Maintain humidity between 90-95% to mimic their natural habitat. Use a humidifier or regularly mist the growing area, ensuring the substrate remains damp but not waterlogged. A humidity dome or tent can help retain moisture, but monitor for condensation to prevent mold or bacterial growth.
Light plays a subtle but important role in fruiting. While *Psilocybe* mushrooms do not require intense light, they need indirect, diffused light to trigger pin formation and proper fruiting body development. Avoid direct sunlight, as it can dry out the substrate and stress the mycelium. A 12-hour photoperiod with fluorescent or LED lights works well, encouraging mushrooms to grow upright and fully formed. Complete darkness can lead to elongated, underdeveloped fruiting bodies.
Temperature is another key factor in fruiting. Most *Psilocybe* species prefer a temperature range of 70-75°F (21-24°C) during this stage. Fluctuations outside this range can stall growth or produce malformed mushrooms. Use a thermostat-controlled environment, such as a grow tent or incubator, to maintain consistency. Avoid placing the setup near drafts, heaters, or air conditioners, as sudden temperature changes can stress the mycelium and hinder fruiting.
Maintaining these conditions requires vigilance and regular monitoring. Invest in tools like a hygrometer, thermometer, and timer to track humidity, temperature, and light cycles. Adjust as needed to create a stable microclimate. Patience is essential, as fruiting can take several weeks after the mycelium has fully colonized the substrate. Proper environmental control ensures healthy, potent mushrooms and minimizes the risk of contamination or failed crops.
Finally, ventilation is often overlooked but crucial for fruiting success. Stagnant air can lead to carbon dioxide buildup, which inhibits mushroom growth. Introduce fresh air by using a small fan on low speed or by periodically opening the humidity dome. This also helps prevent mold and promotes even pin formation. Balancing humidity, light, temperature, and airflow creates the ideal conditions for *Psilocybe* mushrooms to fruit abundantly and develop their psychoactive compounds fully.
Growing Brown Rice Mushrooms: A Simple Step-by-Step Guide
You may want to see also

Harvesting & Storage: Pick mature caps, dry properly, and store in airtight containers for longevity
When growing hallucinogenic mushrooms, timing is critical for harvesting. The caps should be fully mature but not yet releasing spores, as this ensures maximum potency. Look for caps that have expanded fully but still have slightly curled edges or are beginning to flatten. Avoid waiting too long, as overripe mushrooms will drop spores, reducing their quality and making them less desirable for consumption. Gently twist or use a clean, sharp knife to cut the mushroom at the base of the stem to avoid damaging the mycelium, allowing it to continue producing future flushes.
Proper drying is essential to preserve the mushrooms’ potency and prevent mold or decay. Spread the harvested caps and stems on a clean, breathable surface like a wire rack or a mesh screen. Place them in a well-ventilated, dark, and warm area, ideally with temperatures between 60°F and 70°F (15°C to 21°C). A dehumidifier or fan can aid in circulation, but direct sunlight should be avoided, as it degrades the active compounds. Drying can take 24 to 48 hours, depending on humidity levels. The mushrooms are sufficiently dry when they become brittle and snap easily, with no moisture remaining.
Once dried, store the mushrooms in airtight containers to maintain their potency and protect them from moisture, light, and air. Glass jars with rubber-sealed lids or vacuum-sealed bags work best. Ensure the containers are thoroughly clean and dry before use. Label the containers with the harvest date for reference, as potency can diminish over time. Store them in a cool, dark place, such as a pantry or cupboard, away from heat sources or direct sunlight.
For extended longevity, consider storing the airtight containers in a desiccant-filled cabinet or adding silica gel packets to absorb any residual moisture. Properly stored, dried hallucinogenic mushrooms can retain their potency for up to a year or more. However, it’s advisable to inspect them periodically for any signs of mold or degradation, especially if humidity levels fluctuate.
Finally, always handle harvested mushrooms with clean hands and tools to prevent contamination. While the focus is on preserving potency, safety and hygiene are paramount. Proper harvesting and storage not only ensure a longer-lasting product but also maintain the quality and efficacy of the mushrooms for their intended use.
Cultivating Mushrooms: A Beginner's Guide to Growing Your Own Fungi
You may want to see also
Frequently asked questions
The most common hallucinogenic mushrooms are Psilocybe cubensis, Psilocybe semilanceata (Liberty Caps), and Amanita muscaria, though the latter has different effects and risks.
The legality of growing hallucinogenic mushrooms varies by country and region. In many places, it is illegal due to the presence of controlled substances like psilocybin. Always check local laws before attempting to grow them.
The process typically involves sterilizing a substrate (like grain or manure), inoculating it with mushroom spores or mycelium, maintaining proper humidity and temperature, and allowing the mushrooms to fruit in a controlled environment.
You’ll need spores or a spore syringe, a substrate (e.g., rye grain or vermiculite), jars or bags for growing, a pressure cooker for sterilization, a grow chamber, and tools for maintaining humidity and temperature.
Yes, growing them may be illegal in your area, and consuming them can lead to unpredictable psychological effects, physical discomfort, or poisoning if misidentified. Always research thoroughly and proceed with caution.